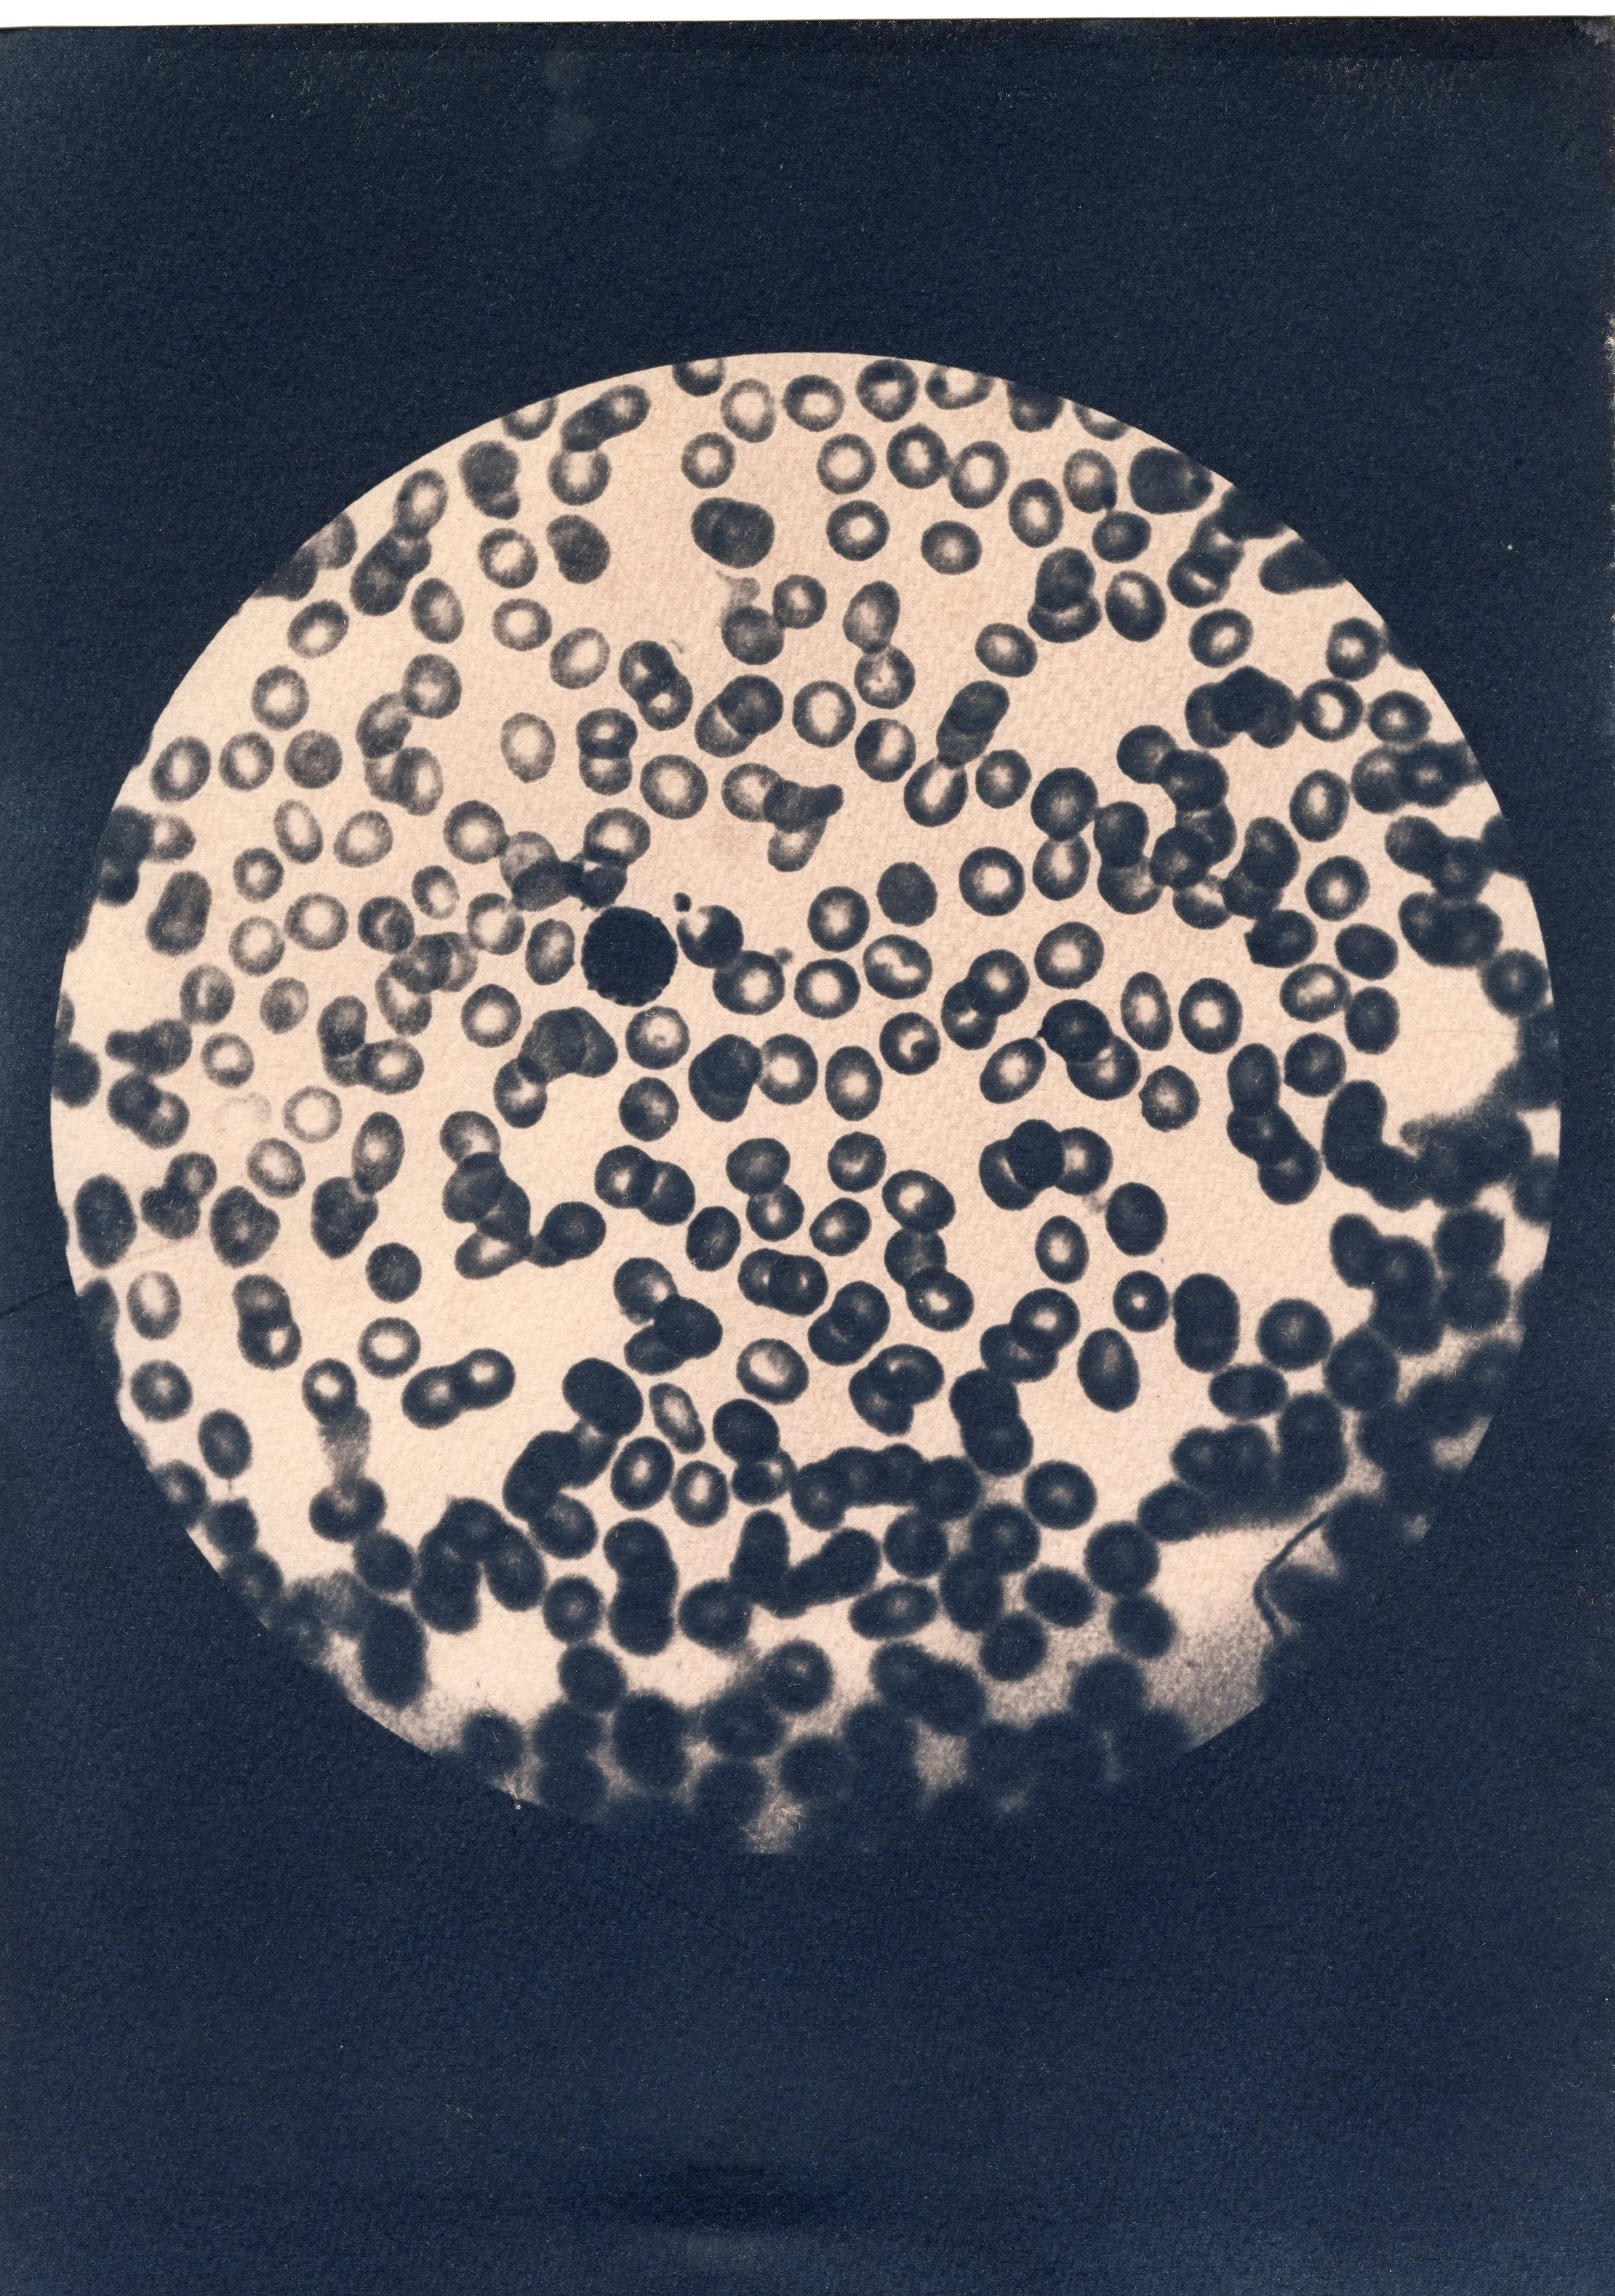

“Endometriosis occurs when cells similar to the ones in the lining of the uterus are found elsewhere in the body. These cells can grow and change in response to hormones in the menstrual cycle, this can cause inflammation, pain and scar tissue.
Endometriosis is most commonly found on the lining of the pelvis and may occur in the ovaries and involve other pelvic organs, like the bowel or bladder. Less commonly, endometriosis can also be found outside the pelvis, such as in the chest.
Endometriosis affects 10% of women and those assigned female at birth from puberty to menopause, although the impact may be felt for life. In the UK, that’s over 1.5 million from all races and ethnicities living with the condition.”
(From the charity Endometriosis UK’s website, 2025)
Endometriosis has been a misdiagnosed and misunderstood disease for many centuries. Historical medical misogyny has resulted in having a residual effect on the present society in which we live, where medical injustices in women’s healthcare remain.
Women’s pain has historically been silenced, with endometriosis being labelled with invented conditions which have systematically oppressed women since 4th century BC. One such invented condition, hysteria, (which was responsible for pathologizing women’s sexuality in the 19th century), is etymologically rooted in the ancient Greek word hystera, meaning uterus, hence the title of this work.
‘Timeline of medical misogyny’ traces the historical ways in which women’s bodies and minds have been controlled and abused in the treatment of what we now know to be endometriosis.